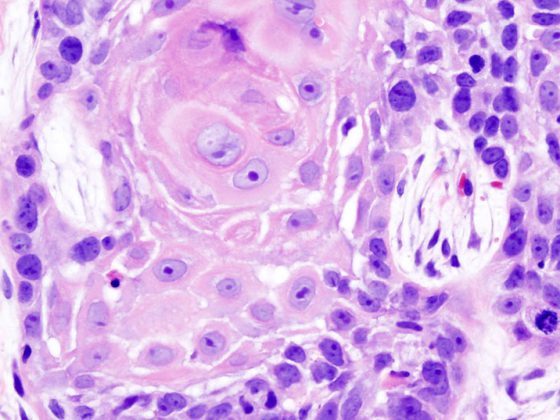
oral_cancer_1_squamous_cell_carcinoma_histopathology

Unsere Darmflora beeinflusst nicht nur die Verdauung, sondern auch unser emotionales Wohlbefinden. Eine aktuelle Studie zeigt: Veränderungen im Mikrobiom können mit Depressionen zusammenhängen – und bestimmte Bakterien sogar antidepressiv wirken. Forschende aus Regensburg und Berlin liefern neue Hinweise auf das Zusammenspiel von Darm, Gehirn und Stimmung.
Dir könnte auch gefallen
- Vom Symptom zur Diagnose
Pneumologie – Covid-19: ein Rückblick
- Altersbedingte neurokognitive Störungen
Neuroprotektive Wirkungen des Ginkgo-biloba-Extrakts
Wie Herkunft und Wohnort den CF-assoziierten Diabetes fördern
- Pankreaskarzinom
Innovative Früherkennung mit Fokus auf Liquid Biopsy und KI
- Vom Symptom zur Diagnose
Abdominalschmerz – Prostataabszess
- Asthma in der Schwangerschaft
Bis zu 40% erleiden Symptomverschlechterung während der Gravidität
- Vom Symptom zur Diagnose
Komplizierte Nierenzysten
- Schweres Asthma und CRSwNP